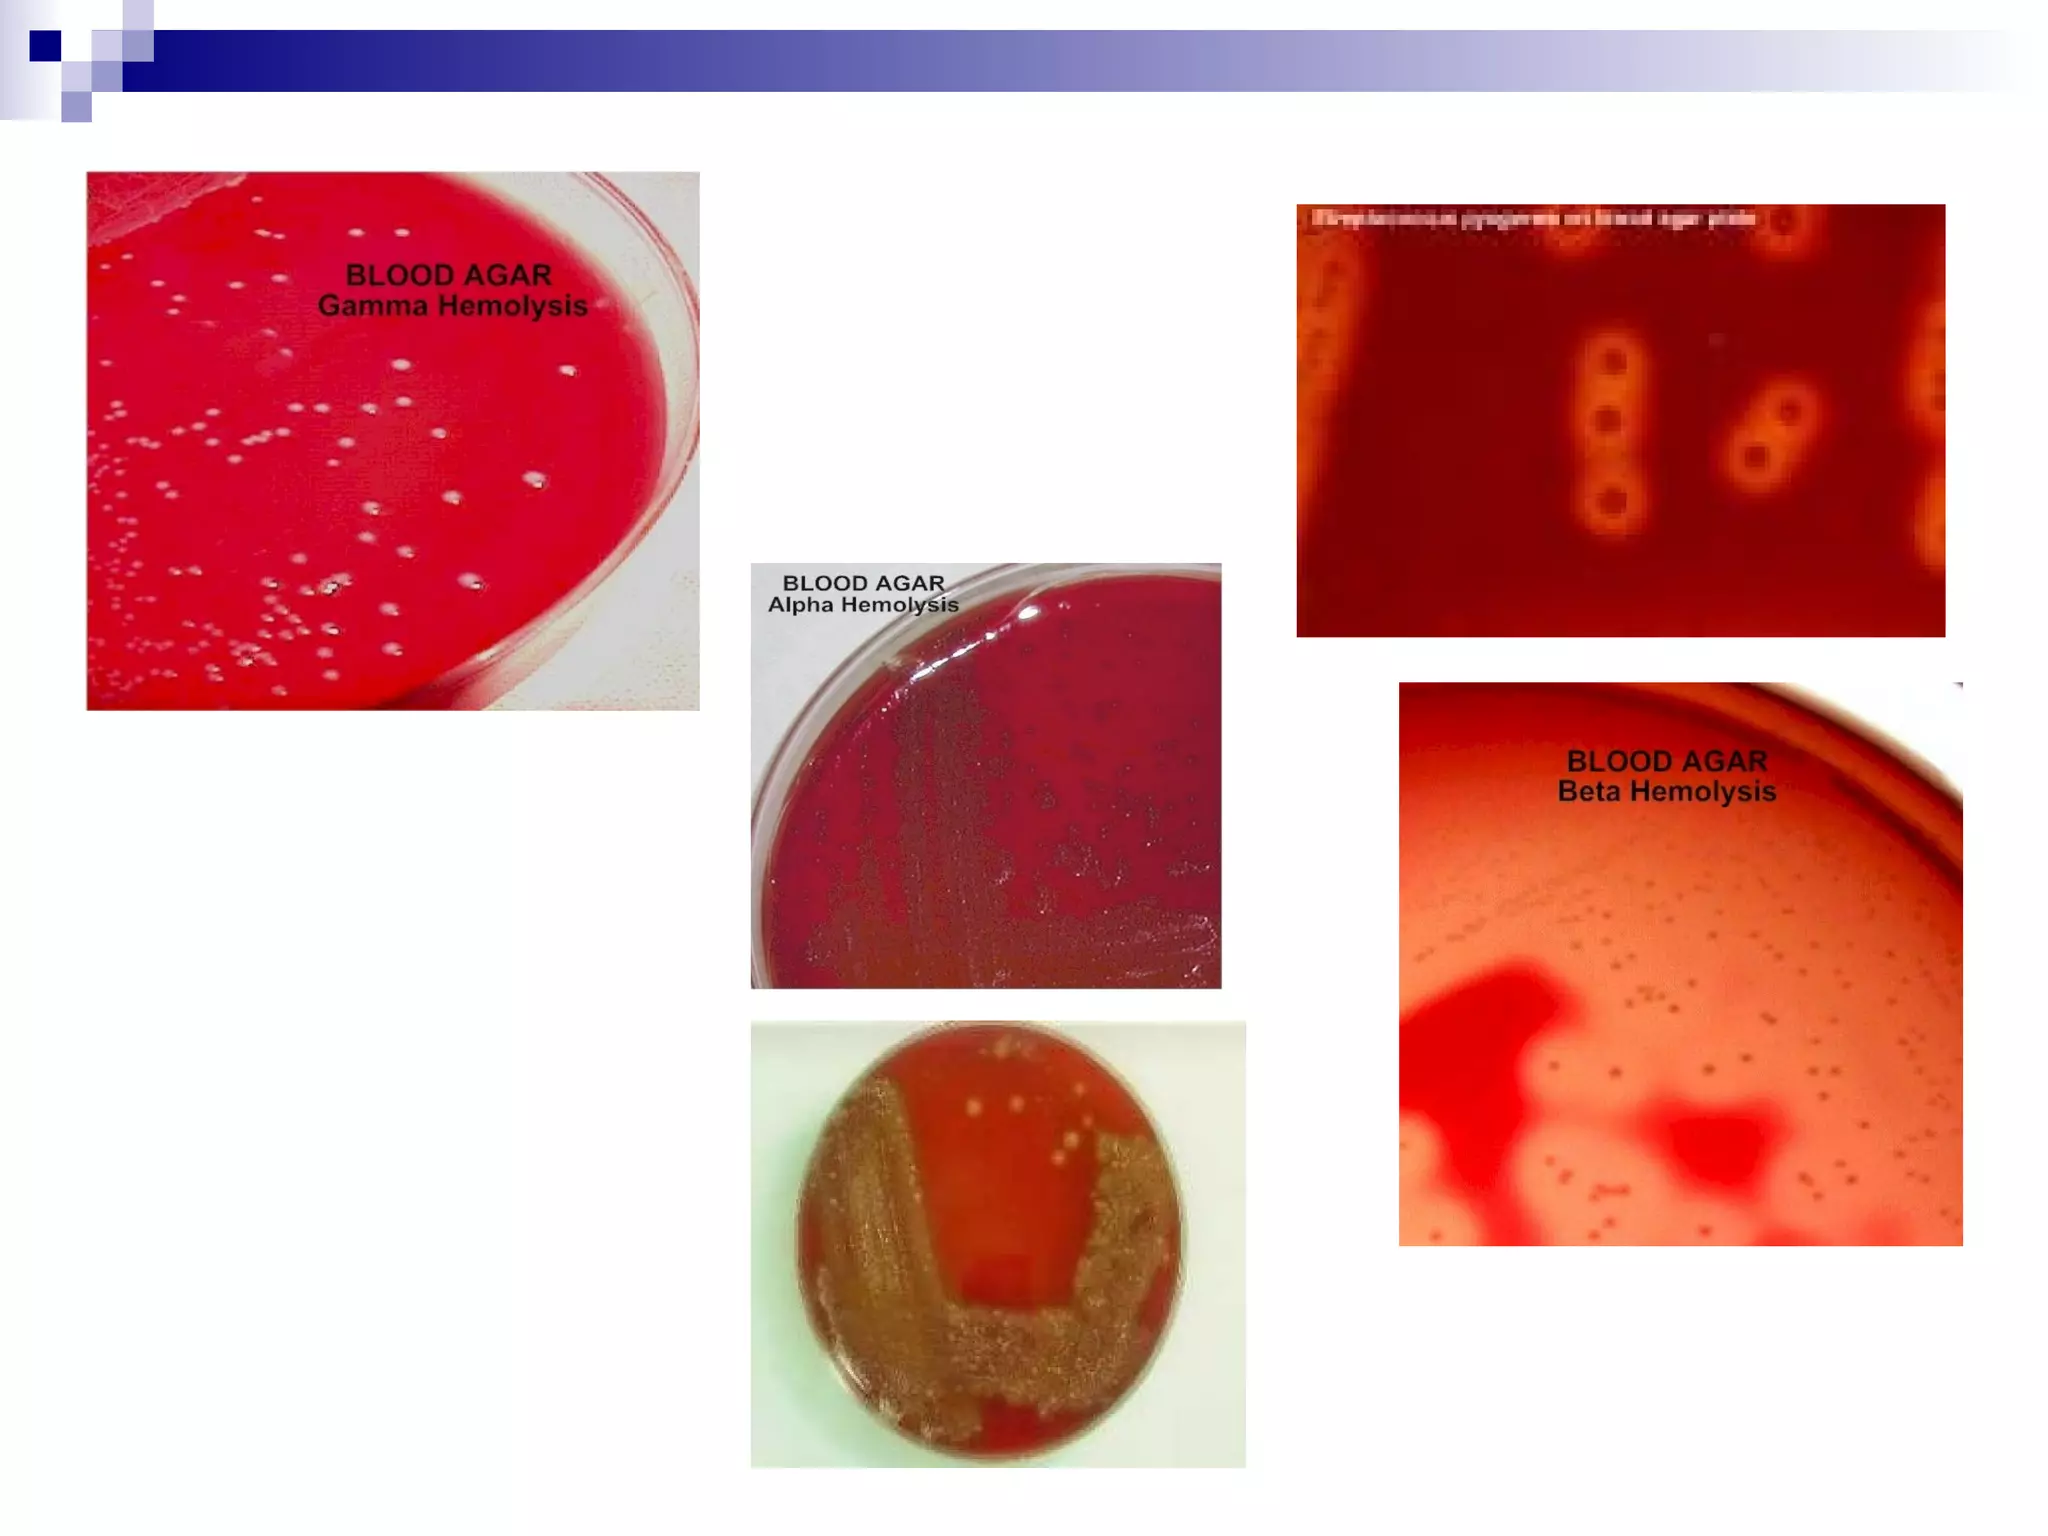
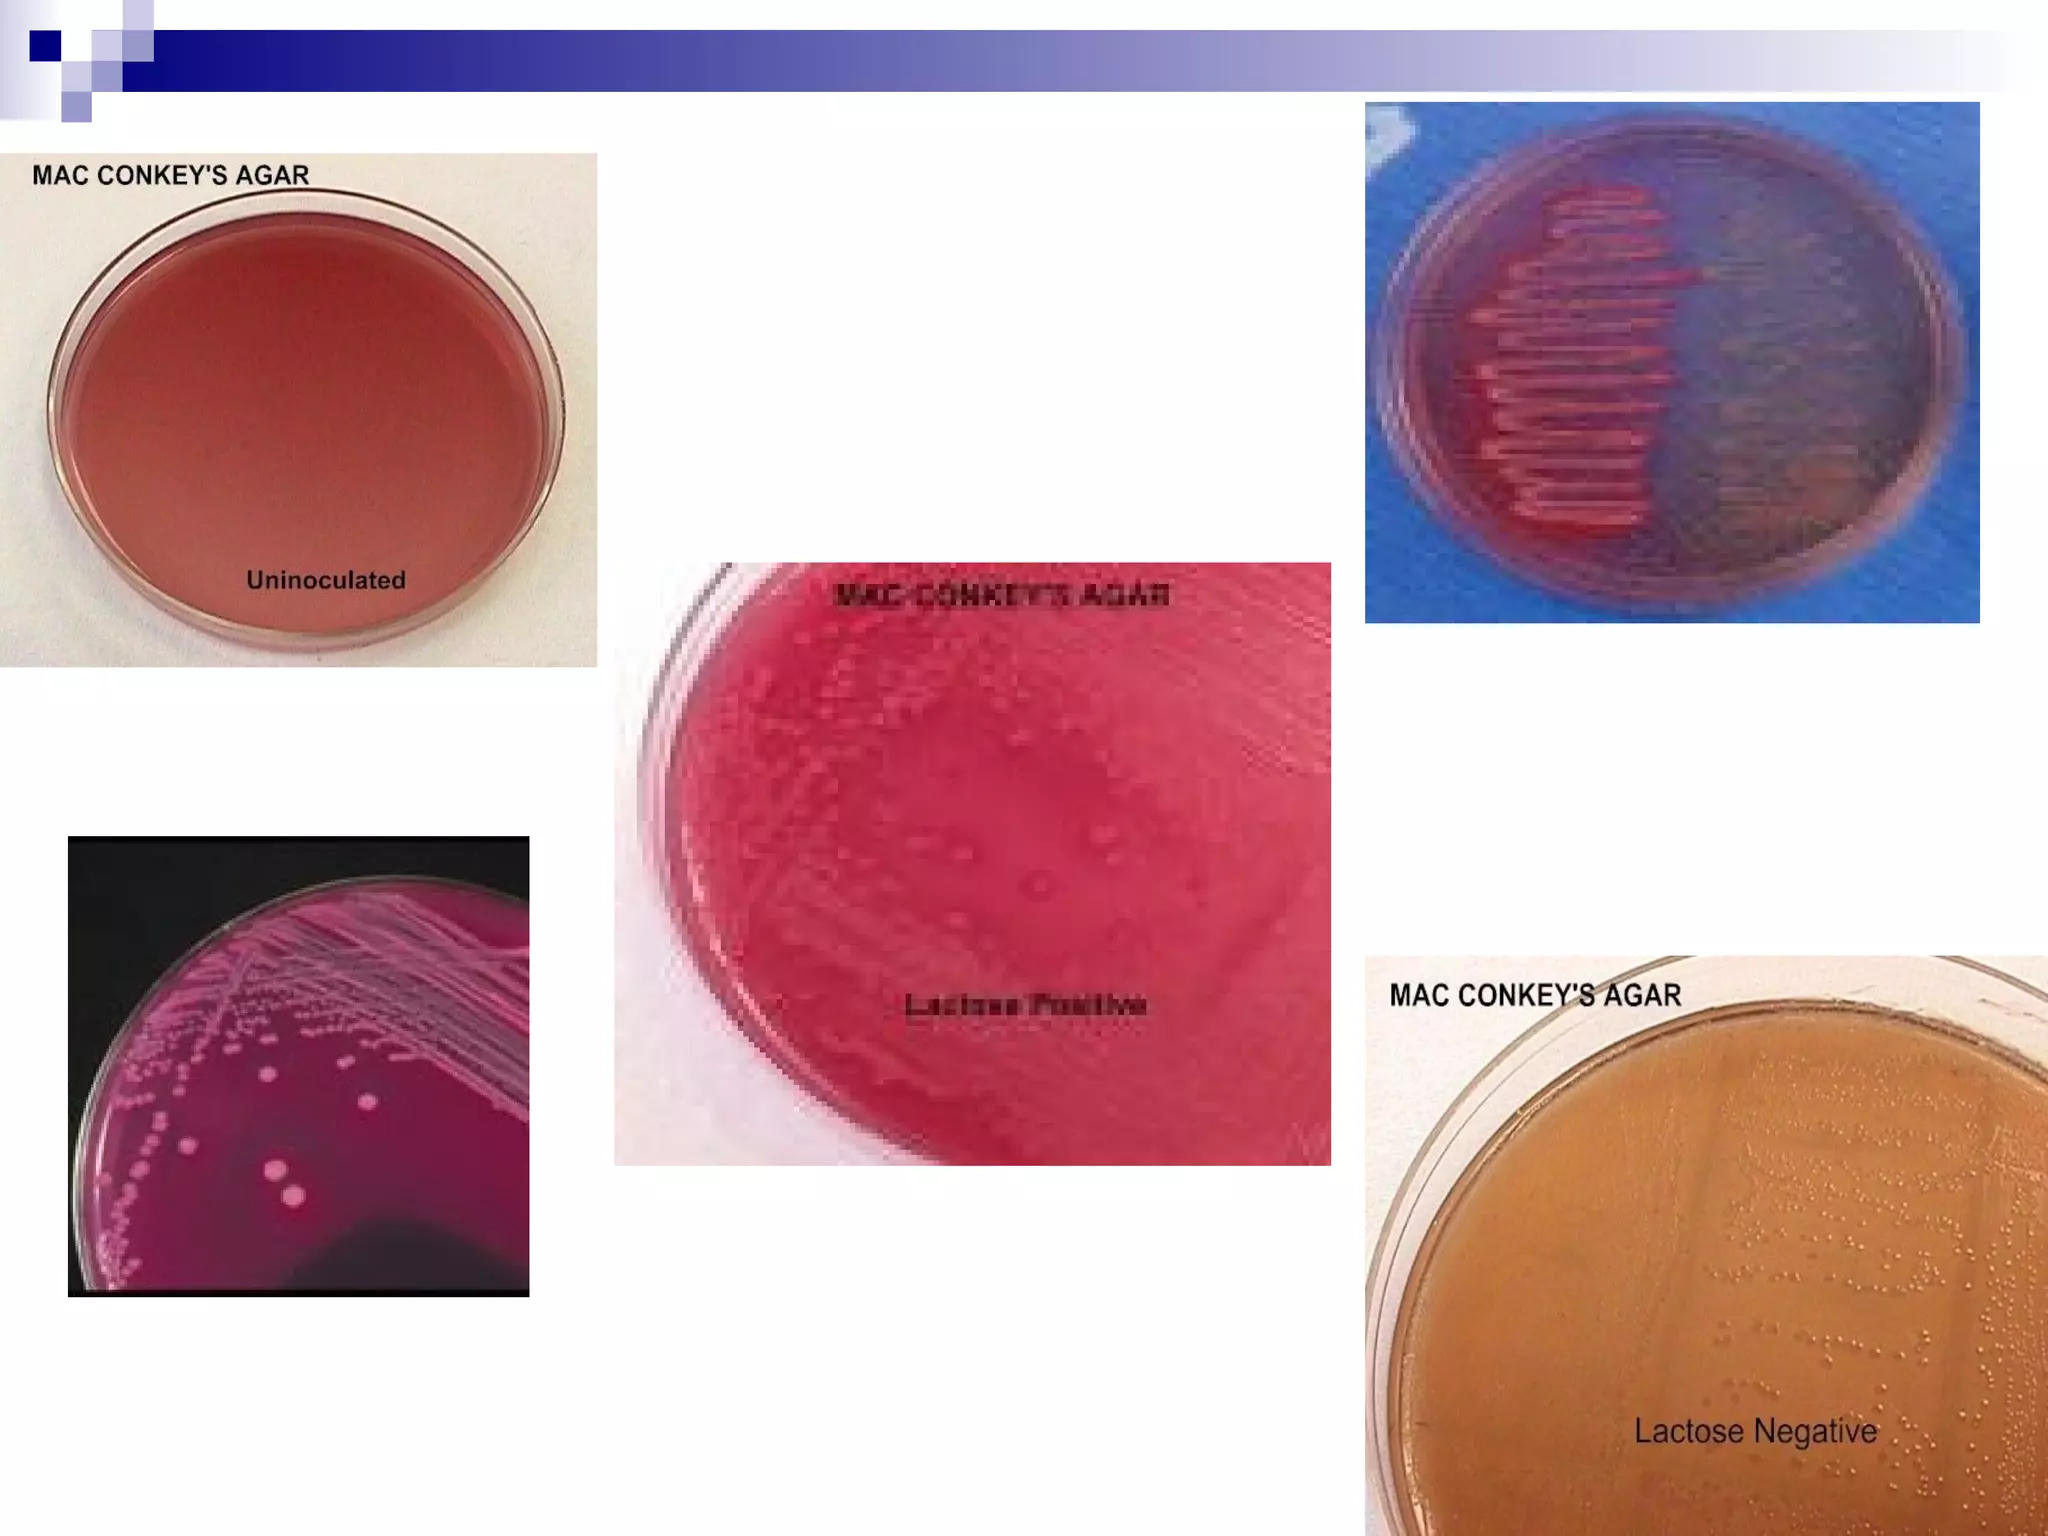
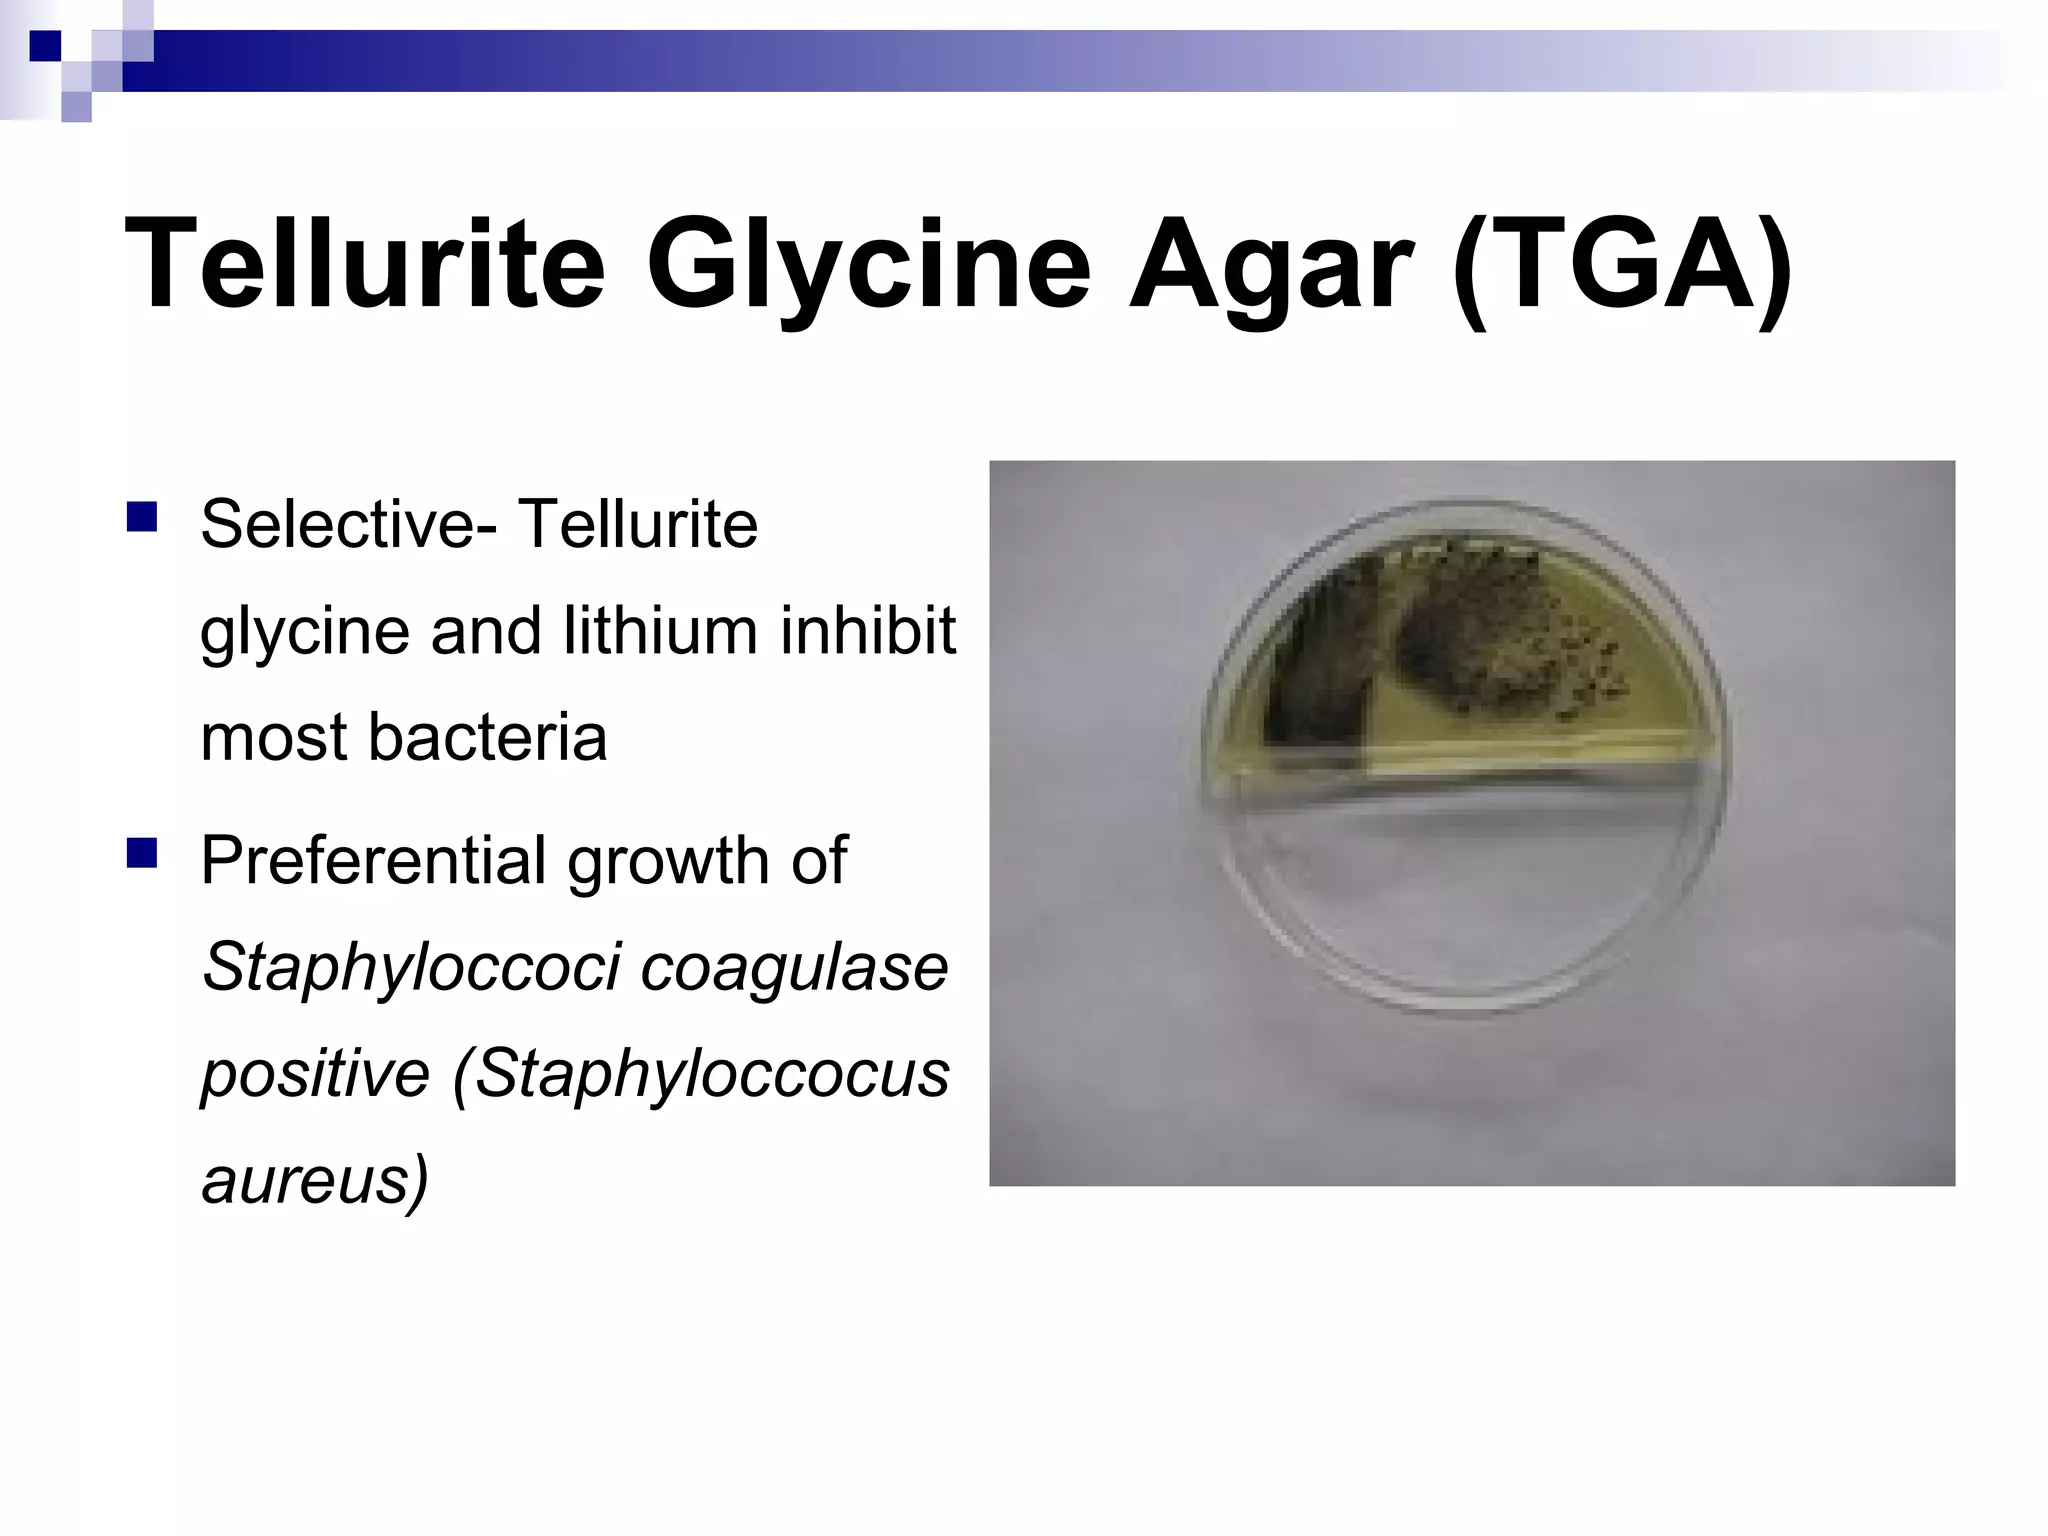
Tellurite Glycine Agar (TGA)
 Selective- Tellurite
glycine and lithium inhibit
most bacteria
 Preferential growth of
Staphyloccoci coagulase
positive (Staphyloccocus
aureus)

This document discusses bacterial cultivation techniques used in lab 13. It describes selective and differential media that are used to isolate and identify bacteria based on their growth characteristics. Various media are described, including blood agar for hemolysis identification, Mannitol salt agar for staphylococcus differentiation, MacConkey agar for gram-negative lactose fermentation, and EMB and TGA for isolation of specific pathogens. The lab activities involve demonstrating these media types and streaking isolated bacteria for identification.